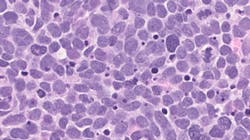
Photo courtesy of NIH and National Cancer Institute Photo courtesy of NIH and National Cancer Institute

Drug testing approach uncovers effective combination for treating small cell lung cancer
Researchers from the National Institutes of Health (NIH have identified and tested a drug combination that exploits a weakness in small cell lung cancer (SCLC), an aggressive, dangerous cancer, reported NIH.
The scientists targeted a vulnerability in how the cancer cells reproduce, increasing already high levels of replication stress – a hallmark of out-of-control cell growth in many cancers that can damage DNA and force cancer cells to constantly work to repair themselves. In a small clinical trial, the drug duo shrank the tumors of SCLC patients. The team reported its findings in Cancer Cell.
While many patients with small cell lung cancer initially respond to chemotherapy, they lack an effective follow-up treatment. These patients usually live a matter of weeks after their first treatment stops working and their disease returns. Scientists at NIH’s National Cancer Institute (NCI) and National Center for Advancing Translational Sciences (NCATS) teamed up to find another option to treat these cancers, which are part of a larger group of similar diseases called small cell neuroendocrine cancers.
“We wanted to identify novel drugs and combinations to leverage this vulnerability therapeutically,” said NCI’s Anish Thomas, M.D., who led the study. “We saw potential opportunities because the armamentarium of new chemicals and drugs was rapidly expanding.”
The NCI group collaborated with NCATS co-author Craig Thomas, Ph.D., and his team to use NCATS’ matrix screening platform and expertise to explore the potential of nearly 3,000 agents from an oncology-focused library of investigational and approved drugs against SCLC cells in the laboratory. NCATS’ robotics-enabled, high-throughput screening technologies allow scientists to rapidly test thousands of different drugs and drug combinations in a variety of ways. Scientists can examine the most promising drugs and drug combinations, determine the most effective doses of each drug and learn more about the possible mechanisms by which these drugs act.
The research team found multiple drug combinations involving commonly used chemotherapy drugs that cause DNA damage and drugs designed to block DNA repair. One of the most effective combinations was the U.S. Food and Drug Administration-approved chemotherapy drug topotecan and an investigational drug M6620, or berzosertib, which blocks an enzyme, called ATR, that plays a role in DNA repair.
“A lot of exciting advances have led to the clinical availability of ATR inhibitors, including berzosertib,” said NCATS translational scientist Michele Ceribelli, Ph.D., a co-author. “Blocking the ATR enzyme means cancer cells can’t respond to DNA damaging agents properly. This makes chemotherapy even more effective.”
The NCI researchers tested the berzosertib-topotecan drug combination in a clinical trial involving SCLC patients who either had relapsed after initial treatment or for whom their therapy had stopped working. They found that the drug combination helped more than one-third of participants (9 of 25) improve in some way. In some cases, the improvement lasted for six months.
“There are a lot of unknowns within the translational process,” said Craig Thomas. “Such large combination screening experiments can reveal pharmacologic relationships from an increasingly diverse collection of compounds and drugs. In the best-case scenario, the outcomes of these screens can help clinical teams prioritize their efforts.”
When the scientists looked more closely at the tumor samples, they discovered that the patients whose tumors became smaller in response to treatment showed more activity in genes involved in rapid cell growth and DNA repair. The findings suggest that researchers could develop a more personalized approach in treating SCLC patients as well as other types of small cell neuroendocrine cancers.
As a next step, NCI is sponsoring a larger clinical trial to compare the effects of berzosertib and topotecan in combination against topotecan alone in SCLC patients.